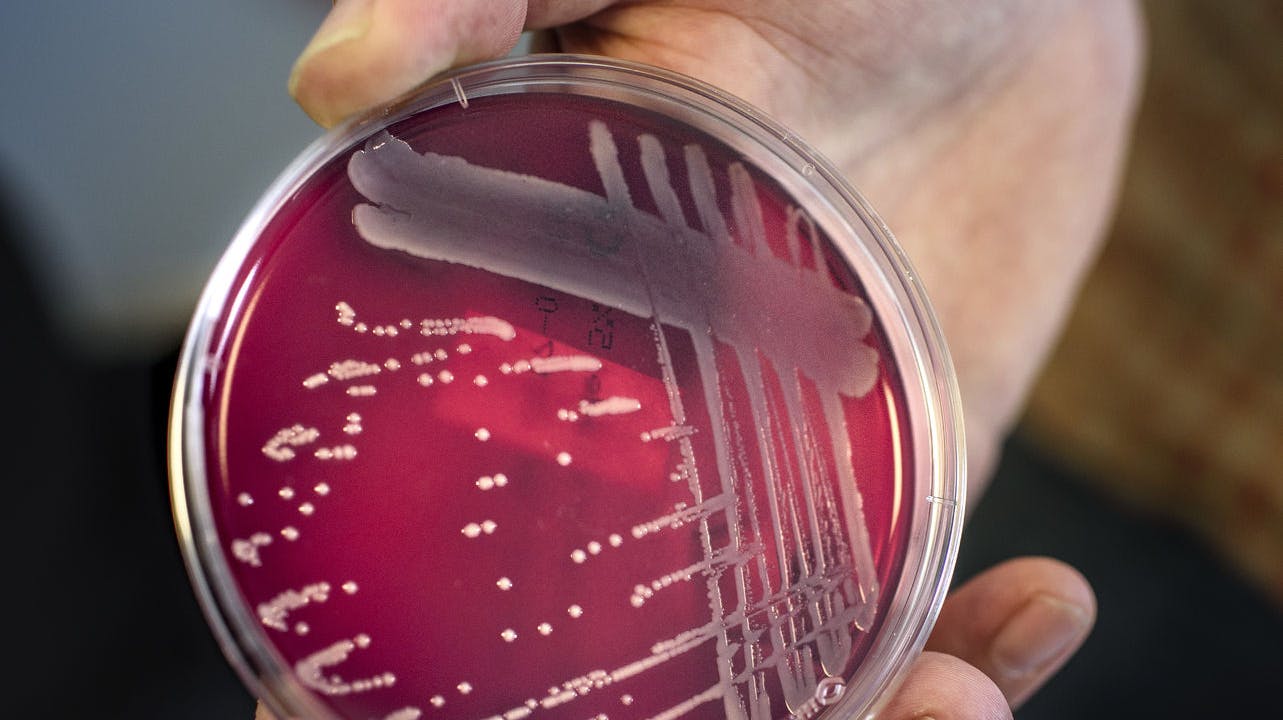
Statens Serum Institut oplyser, at invasive tilfælde af streptokokker har kostet mindst 35 danskere livet siden december.

Nyheder3. mar. 2023
Streptokokker har kostet mindst 35 danskere livet - to er under 15 år
Mindst 35 danskere har de seneste måneder mistet livet til streptokokker - blandt ofrene er to børn under 15 år
Af Ritzau
Statens Serum Institut oplyser, at invasive tilfælde af streptokokker har kostet mindst 35 danskere livet siden december.
Foto: Scanpix DenmarkAnnonce
Invasive tilfælde af streptokokker har siden december kostet mindst 35 danskere livet.
Det oplyser Statens Serum Institut til TV 2.
Blandt de døde er to børn under 15 år, skriver TV 2.
Siden december har SSI observeret en kraftig stigning i tilfælde med gruppe a-streptokokker. Herunder også en øget forekomst af de invasive tilfælde.
De invasive tilfælde er de tilfælde, hvor streptokokker har spredt sig og forårsaget alvorlige tilstande såsom blodforgiftning.
Opdateres...